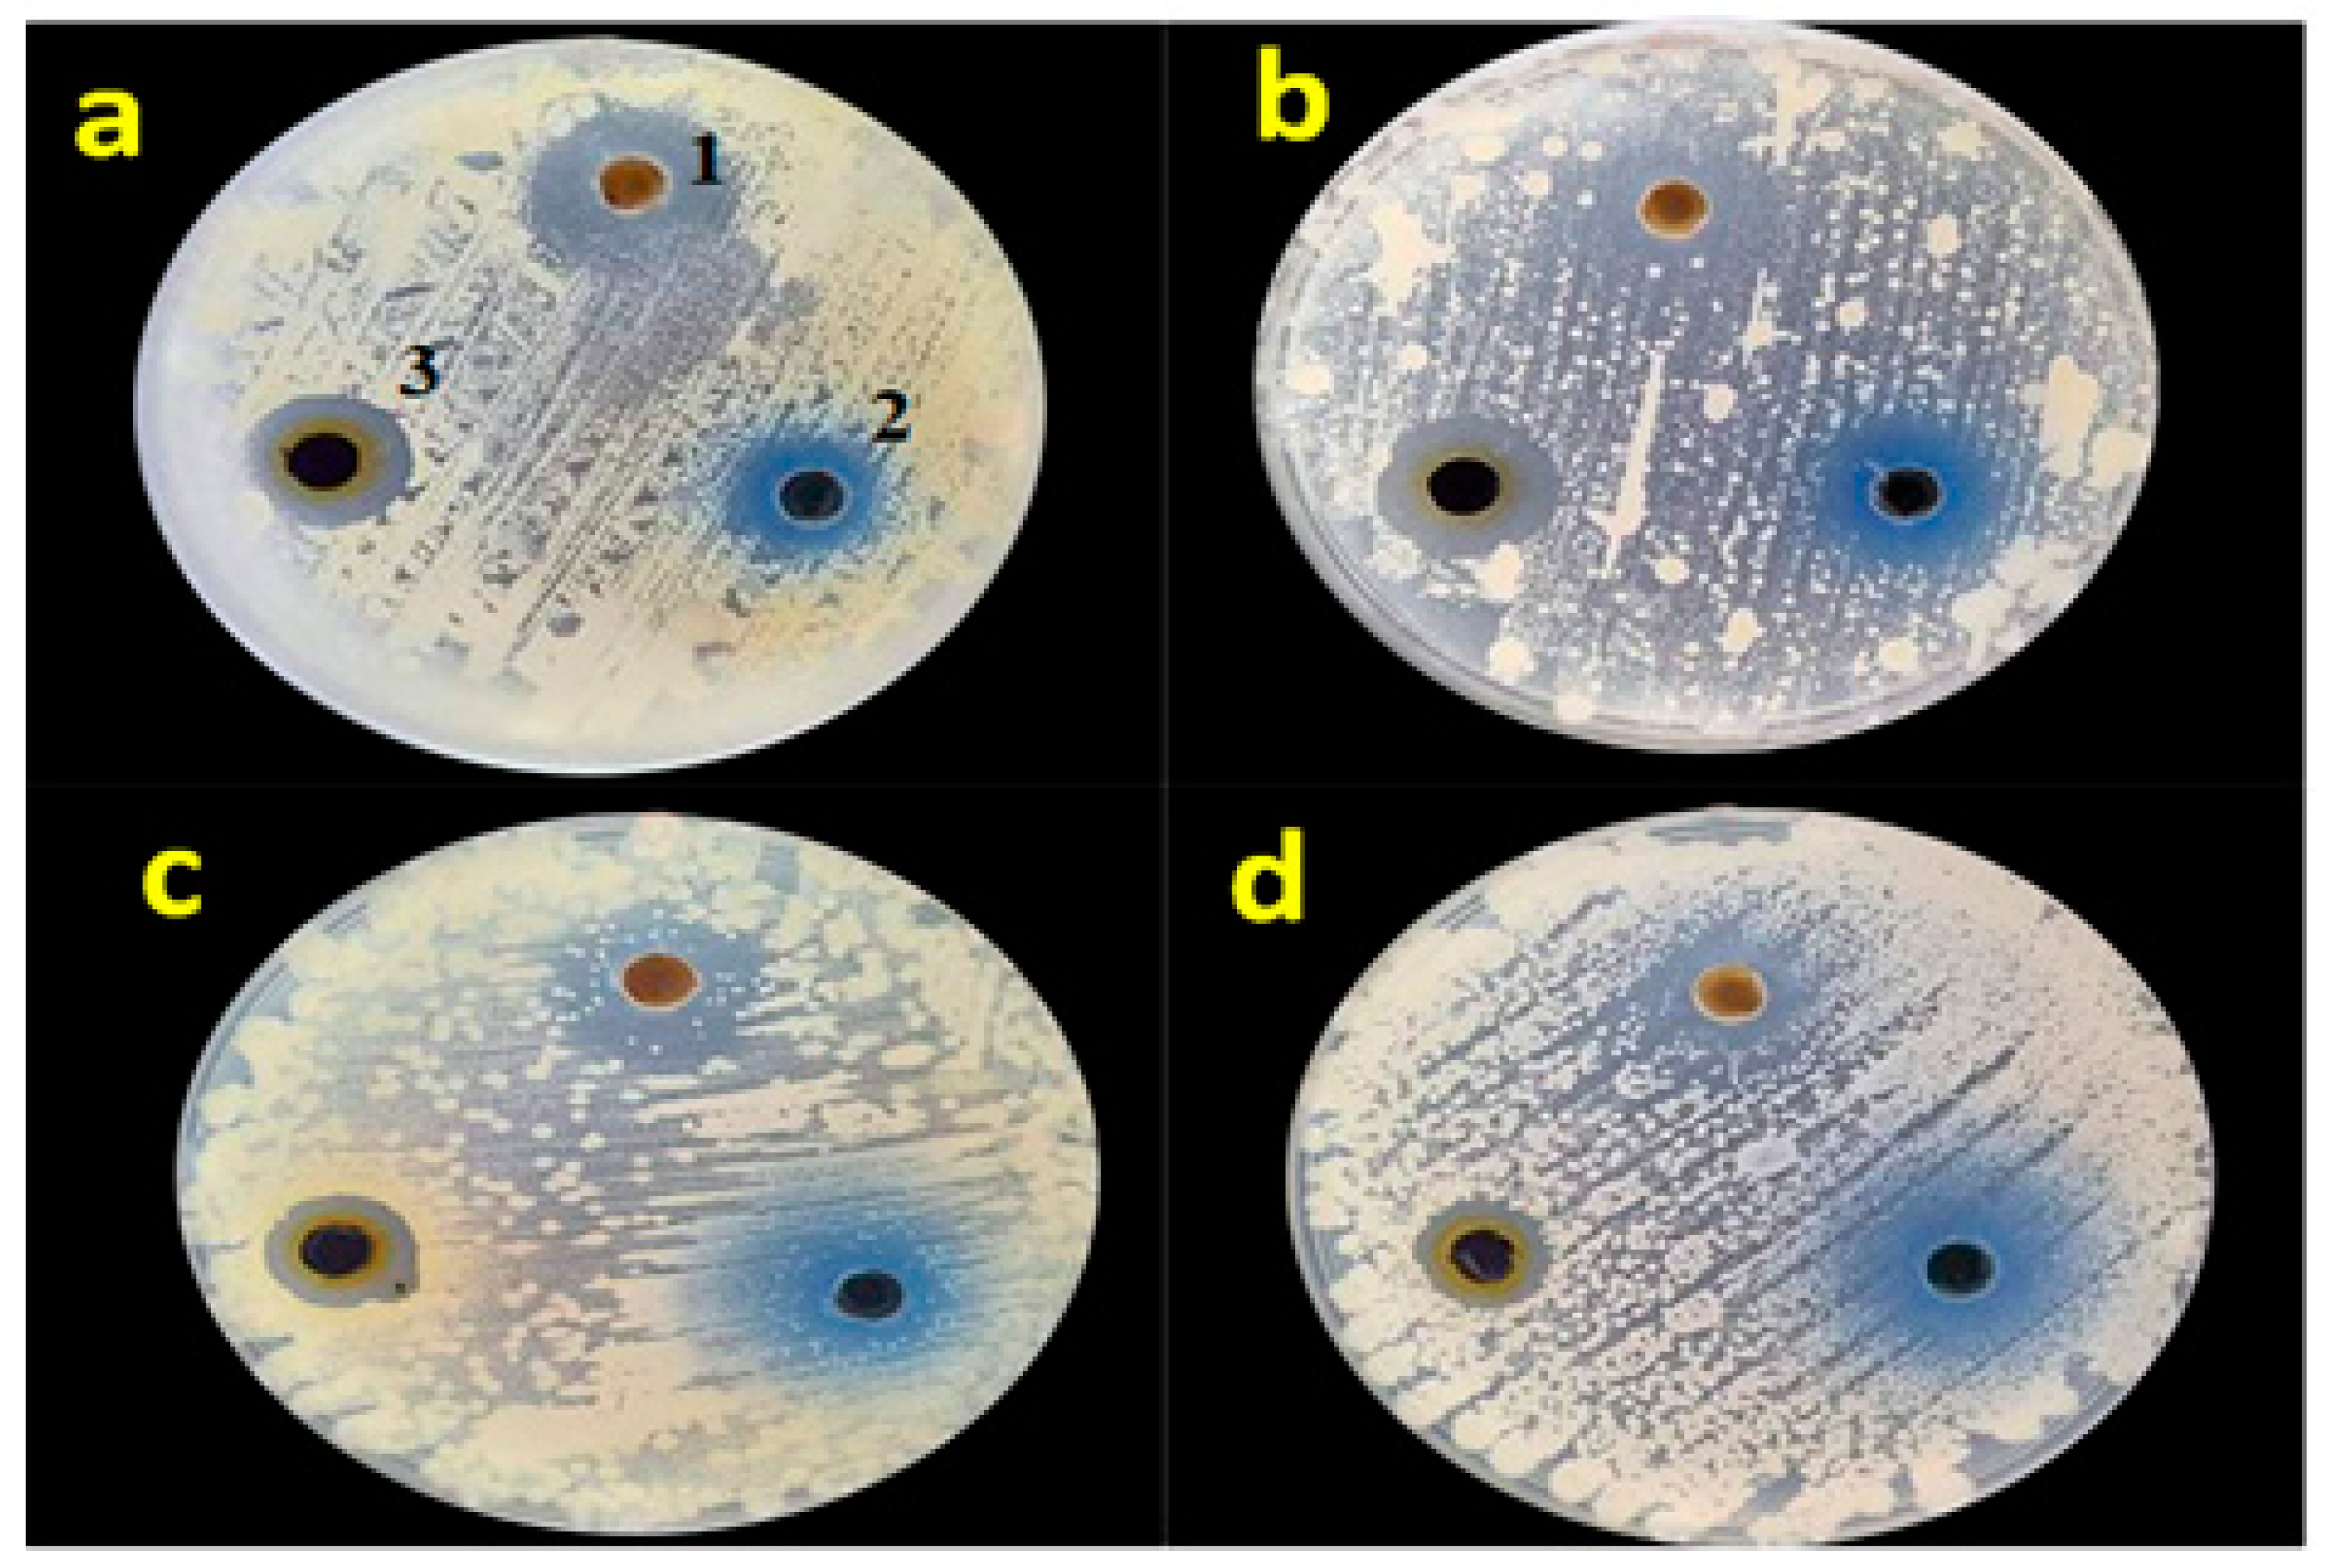
Catalysts 15 00407 g011

MNP (M = Zn, Cu, and Ag) Catalyst Embedded onto Zeolite Y Surface for Efficient Dye Reduction and Antimicrobial Activity
Abstract
1. Introduction
2. Results
2.1. XRD Analysis
2.2. FTIR
2.3. UV-Vis Reflectance Spectroscopy
2.4. SEM/TEM
3. Catalytic Application of MNPs/Y
3.1. Effect of Nanocatalyst Nature
3.2. Effect of Catalyst Masse
3.3. Effect of Reagent Concentration
3.4. Reduction of Azo Dye (OG)
3.5. Reduction of MB and OG in a Binary System
3.6. Reuse of Catalyst Ag/Y
3.7. Reaction Mechanism
4. Antifungal and Antibacterial Activities
5. Experimental
5.1. Chemicals and Reagents
5.2. Preparation of Zeolite Y
5.3. Preparation of MNPs/Zeolite Y
5.4. Hydrogenation Reaction of MB Dye
5.5. Hydrogenation of a Mixture of Dyes MB + OG
5.6. Methylene Blue (MB) Adsorption Test
6. Conclusions
Supplementary Materials
Author Contributions
Funding
Data Availability Statement
Conflicts of Interest
References
- Speight, J.G. 5—Sources of Water Pollution. In Natural Water Remediation; Speight, J.G., Ed.; Butterworth-Heinemann: Oxford, UK, 2020; pp. 165–198. ISBN 978-0-12-803810-9. [Google Scholar]
- Shukla, S.R. 6—Pollution Abatement and Waste Minimisation in Textile Dyeing. In Environmental Aspects of Textile Dyeing; Christie, R.M., Ed.; Woodhead Publishing: Sawston, UK, 2007; pp. 116–148. ISBN 978-1-84569-115-8. [Google Scholar]
- Liu, Y.; Wang, P.; Gojenko, B.; Yu, J.; Wei, L.; Luo, D.; Xiao, T. A Review of Water Pollution Arising from Agriculture and Mining Activities in Central Asia: Facts, Causes and Effects. Environ. Pollut. 2021, 291, 118209. [Google Scholar] [CrossRef] [PubMed]
- Hussain, C.M.; Keçili, R. Chapter 1—Environmental Pollution and Environmental Analysis. In Modern Environmental Analysis Techniques for Pollutants; Hussain, C.M., Keçili, R., Eds.; Elsevier: Amsterdam, The Netherlands, 2020; pp. 1–36. ISBN 978-0-12-816934-6. [Google Scholar]
- Josephy, P.D.; Allen-Vercoe, E. Reductive Metabolism of Azo Dyes and Drugs: Toxicological Implications. Food Chem. Toxicol. 2023, 178, 113932. [Google Scholar] [CrossRef]
- Barciela, P.; Perez-Vazquez, A.; Prieto, M.A. Azo Dyes in the Food Industry: Features, Classification, Toxicity, Alternatives, and Regulation. Food Chem. Toxicol. 2023, 178, 113935. [Google Scholar] [CrossRef] [PubMed]
- Ibrahim, S.M.; Al-Hossainy, A.F.; Saha, B.; El-Aal, M.A. Removal of Bromothymol Blue Dye by the Oxidation Method Using KMnO4: Accelerating the Oxidation Reaction by Ru (III) Catalyst. J. Mol. Struct. 2022, 1268, 133679. [Google Scholar] [CrossRef]
- Jiang, L.; Lu, Q.; Chen, H.; Su, Y.; Zeng, G.; Li, M.; Xie, S.; Wang, X.; Li, W.; Yuan, X.; et al. Visible Light-Activated Porphyrinic Zirconium Metal-Organic Framework for Ultrafast Photo-Fenton-like Reaction: Efficient Internal and External Conduction Mechanism of Photogenerated Electrons. Sep. Purif. Technol. 2025, 362, 131937. [Google Scholar] [CrossRef]
- Abdelhameed, R.M.; El-Shahat, M.; Emam, H.E. Employable Metal (Ag & Pd)@MIL-125-NH2@cellulose Acetate Film for Visible-Light Driven Photocatalysis for Reduction of Nitro-Aromatics. Carbohydr. Polym. 2020, 247, 116695. [Google Scholar] [CrossRef] [PubMed]
- Jiang, L.; Xie, S.; Chen, H.; Yang, J.; Wang, X.; Li, W.; Peng, X.; Wu, Z.; Wang, H.; Wang, J.; et al. Visible-Light-Promoted Peroxymonosulfate Activation for ACE Degradation: Overlooked Role of Photogenerated Hole. Appl. Catal. B Environ. Energy 2025, 365, 124881. [Google Scholar] [CrossRef]
- Wang, F.; Ren, J.; Cai, Y.; Sun, L.; Chen, C.; Liang, S.; Jiang, X. Palladium Nanoparticles Confined within ZSM-5 Zeolite with Enhanced Stability for Hydrogenation of p-Nitrophenol to p-Aminophenol. Chem. Eng. J. 2016, 283, 922–928. [Google Scholar] [CrossRef]
- Ullah, K.; Khan, S.; Khan, M.; Rahman, Z.U.; Al-Ghamdi, Y.O.; Mahmood, A.; Hussain, S.; Khan, S.B.; Khan, S.A. A Bioresource Catalyst System of Alginate-Starch-Activated Carbon Microsphere Templated Cu Nanoparticles: Potentials in Nitroarenes Hydrogenation and Dyes Discoloration. Int. J. Biol. Macromol. 2022, 222, 887–901. [Google Scholar] [CrossRef]
- Mascarenhas, B.C.; Varanda, L.C. Catalytic Hydrogenation of Organic Dyes by Ag Nanoparticles on Reduced Graphene Oxide. J. Ind. Eng. Chem. 2021, 103, 124–135. [Google Scholar] [CrossRef]
- Kassem, A.A.; Abdelhamid, H.N.; Fouad, D.M.; Ibrahim, S.A. Hydrogenation Reduction of Dyes Using Metal-Organic Framework-Derived CuO@C. Microporous Mesoporous Mater. 2020, 305, 110340. [Google Scholar] [CrossRef]
- Fu, Y.; Qin, L.; Huang, D.; Zeng, G.; Lai, C.; Li, B.; He, J.; Yi, H.; Zhang, M.; Cheng, M.; et al. Chitosan Functionalized Activated Coke for Au Nanoparticles Anchoring: Green Synthesis and Catalytic Activities in Hydrogenation of Nitrophenols and Azo Dyes. Appl. Catal. B Environ. 2019, 255, 117740. [Google Scholar] [CrossRef]
- Song, Y.; Yang, L.-Y.; Wang, Y.; Yu, D.; Shen, J.; Ouyang, X. Highly Efficient Adsorption of Pb(II) from Aqueous Solution Using Amino-Functionalized SBA-15/Calcium Alginate Microspheres as Adsorbent. Int. J. Biol. Macromol. 2019, 125, 808–819. [Google Scholar] [CrossRef]
- Hachemaoui, M.; Boukoussa, B.; Mokhtar, A.; Mekki, A.; Beldjilali, M.; Benaissa, M.; Zaoui, F.; Hakiki, A.; Chaibi, W.; Sassi, M.; et al. Dyes Adsorption, Antifungal and Antibacterial Properties of Metal Loaded Mesoporous Silica: Effect of Metal and Calcination Treatment. Mater. Chem. Phys. 2020, 256, 123704. [Google Scholar] [CrossRef]
- Dermiki, M.; Garrard, I.J.; Jauregi, P. Selective Separation of Dyes by Colloidal Gas Aphrons: Conventional Flotation vs Countercurrent Chromatography. Sep. Purif. Technol. 2021, 279, 119770. [Google Scholar] [CrossRef]
- Mantasha, I.; Saleh, H.A.M.; Qasem, K.M.A.; Shahid, M.; Mehtab, M.; Ahmad, M. Efficient and Selective Adsorption and Separation of Methylene Blue (MB) from Mixture of Dyes in Aqueous Environment Employing a Cu(II) Based Metal Organic Framework. Inorganica Chim. Acta 2020, 511, 119787. [Google Scholar] [CrossRef]
- Badawi, A.K.; Zaher, K. Hybrid Treatment System for Real Textile Wastewater Remediation Based on Coagulation/Flocculation, Adsorption and Filtration Processes: Performance and Economic Evaluation. J. Water Process Eng. 2021, 40, 101963. [Google Scholar] [CrossRef]
- Ihaddaden, S.; Aberkane, D.; Boukerroui, A.; Robert, D. Removal of Methylene Blue (Basic Dye) by Coagulation-Flocculation with Biomaterials (Bentonite and Opuntia Ficus Indica). J. Water Process Eng. 2022, 49, 102952. [Google Scholar] [CrossRef]
- Kumar, V.; Thakur, C.; Chaudhari, P.K. Anaerobic Biological Treatment of Dye Bearing Water in Anaerobic Sequencing Batch Reactor: Performance and Kinetics Studies. J. Indian Chem. Soc. 2022, 99, 100673. [Google Scholar] [CrossRef]
- Singh, A.; Pal, D.B.; Mohammad, A.; Alhazmi, A.; Haque, S.; Yoon, T.; Srivastava, N.; Gupta, V.K. Biological Remediation Technologies for Dyes and Heavy Metals in Wastewater Treatment: New Insight. Bioresour. Technol. 2022, 343, 126154. [Google Scholar] [CrossRef]
- Khan, S.B.; Bakhsh, E.M.; Akhtar, K.; Kamal, T.; Shen, Y.; Asiri, A.M. Copper Oxide-Antimony Oxide Entrapped Alginate Hydrogel as Efficient Catalyst for Selective Reduction of 2-Nitrophenol. Polymers 2022, 14, 458. [Google Scholar] [CrossRef] [PubMed]
- Khan, S.B.; Akhtar, K.; Bakhsh, E.M.; Kamal, T.; Asiri, A.M. Alginate Biopolymer as a Reactor Container for Copper Oxide-Tin Oxide: Efficient Nanocatalyst for Reduction of Different Pollutants. Chemosphere 2022, 291, 132811. [Google Scholar] [CrossRef]
- Khan, S.B.; Ahmad, S.; Kamal, T.; Asiri, A.M.; Bakhsh, E.M. Metal Nanoparticles Decorated Sodium Alginate-carbon Nitride Composite Beads as Effective Catalyst for the Reduction of Organic Pollutants. Int. J. Biol. Macromol. 2020, 164, 1087–1098. [Google Scholar] [CrossRef] [PubMed]
- Kamal, T.; Khan, M.S.J.; Khan, S.B.; Asiri, A.M.; Chani, M.T.S.; Ullah, M.W. Silver Nanoparticles Embedded in Gelatin Biopolymer Hydrogel as Catalyst for Reductive Degradation of Pollutants. J. Polym. Environ. 2020, 28, 399–410. [Google Scholar] [CrossRef]
- Yuan, G.; Li, K.; Zhang, J.; Yang, G.; Wu, J.; Li, F.; Zhang, H.; Wang, J.; Zhang, S.; Jia, Q. Carbon cloth@SnS2 Nanosheet Array Catalysts for Efficient Microwave Induced Catalytic Reduction of Cr(VI): Experiment and DFT Study. J. Environ. Chem. Eng. 2023, 11, 109880. [Google Scholar] [CrossRef]
- Yu, L.; Li, D.; Xu, Z.; Zheng, S. Polyaniline Coated Pt/CNT as Highly Stable and Active Catalyst for Catalytic Hydrogenation Reduction of Cr(VI). Chemosphere 2023, 310, 136685. [Google Scholar] [CrossRef] [PubMed]
- Wang, Y.; Kang, C.; Li, X.; Hu, Q.; Wang, C. Ag NPs Decorated C–TiO2/Cd0.5Zn0.5S Z-Scheme Heterojunction for Simultaneous RhB Degradation and Cr(VI) Reduction. Environ. Pollut. 2021, 286, 117305. [Google Scholar] [CrossRef]
- Hachemaoui, M.; Mokhtar, A.; Ismail, I.; Mohamedi, M.W.; Iqbal, J.; Taha, I.; Bennabi, F.; Zaoui, F.; Bengueddach, A.; Hamacha, R.; et al. M (M: Cu, Co, Cr or Fe) Nanoparticles-Loaded Metal-Organic Framework MIL-101(Cr) Material by Sonication Process: Catalytic Activity and Antibacterial Properties. Microporous Mesoporous Mater. 2021, 323, 111244. [Google Scholar] [CrossRef]
- Hachemaoui, M.; Boukoussa, B.; Ismail, I.; Mokhtar, A.; Taha, I.; Iqbal, J.; Hacini, S.; Bengueddach, A.; Hamacha, R. CuNPs-Loaded Amines-Functionalized-SBA-15 as Effective Catalysts for Catalytic Reduction of Cationic and Anionic Dyes. Colloids Surf. A Physicochem. Eng. Asp. 2021, 623, 126729. [Google Scholar] [CrossRef]
- Benhadria, N.; Hachemaoui, M.; Zaoui, F.; Mokhtar, A.; Boukreris, S.; Attar, T.; Belarbi, L.; Boukoussa, B. Catalytic Reduction of Methylene Blue Dye by Copper Oxide Nanoparticles. J. Clust. Sci. 2022, 33, 249–260. [Google Scholar] [CrossRef]
- Mekki, A.; Hachemaoui, M.; Mokhtar, A.; Issam, I.; Bennabi, F.; Iqbal, J.; Rahmani, K.; Bengueddach, A.; Boukoussa, B. Catalytic Behavior and Antibacterial/Antifungal Activities of New MNPs/Zeolite@alginate Composite Beads. Int. J. Biol. Macromol. 2022, 198, 37–45. [Google Scholar] [CrossRef] [PubMed]
- Naseem, K.; Begum, R.; Farooqi, Z.H. Catalytic Reduction of 2-Nitroaniline: A Review. Environ. Sci. Pollut. Res. 2017, 24, 6446–6460. [Google Scholar] [CrossRef]
- Farooqi, Z.H.; Begum, R.; Naseem, K.; Wu, W.; Irfan, A. Zero Valent Iron Nanoparticles as Sustainable Nanocatalysts for Reduction Reactions. Catal. Rev. 2022, 64, 286–355. [Google Scholar] [CrossRef]
- Farooq, M.; Shujah, S.; Tahir, K.; Nazir, S.; Ullah Khan, A.; Almarhoon, Z.M.; Jevtovic, V.; Al-Shehri, H.S.; Tasleem Hussain, S.; Ullah, A. Ultra Efficient 4-Nitrophenol Reduction, Dye Degradation and Cr(VI) Adsorption in the Presence of Phytochemical Synthesized Ag/ZnO Nanocomposite: A View towards Sustainable Chemistry. Inorg. Chem. Commun. 2022, 136, 109189. [Google Scholar] [CrossRef]
- Khan, S.A.; Mohammed, S.A.; Bakhsh, E.M.; Al-Ghamdi, Y.O.; Rauf, A.; Akhtar, K.; Begum, A.; Khan, S.B. Reduction of Nitrophenol Isomers and Degradation of Azo Dyes through Zero-Valent Ni Nanoparticles Anchored on Cellulose Acetate Coated Ce/Zr Composite. J. Water Process Eng. 2021, 44, 102383. [Google Scholar] [CrossRef]
- Mekki, A.; Benmaati, A.; Mokhtar, A.; Hachemaoui, M.; Zaoui, F.; Zahmani, H.H.; Sassi, M.; Hacini, S.; Boukoussa, B. Michael Addition of 1,3-Dicarbonyl Derivatives in the Presence of Zeolite Y as an Heterogeneous Catalyst. J. Inorg. Organomet. Polym. Mater. 2020, 30, 2323–2334. Available online: https://link.springer.com/article/10.1007/s10904-019-01424-5 (accessed on 26 February 2024). [CrossRef]
- Tatlier, M.; Atalay-Oral, C.; Bayrak, A.; Maraş, T.; Erdem, A. Impact of Ion Exchange on Zeolite Hydrophilicity/Hydrophobicity Monitored by Water Capacity Using Thermal Analysis. Thermochim. Acta 2022, 713, 179240. [Google Scholar] [CrossRef]
- Mekki, A.; Mokhtar, A.; Hachemaoui, M.; Beldjilali, M.; Meliani, M.f.; Zahmani, H.H.; Hacini, S.; Boukoussa, B. Fe and Ni Nanoparticles-Loaded Zeolites as Effective Catalysts for Catalytic Reduction of Organic Pollutants. Microporous Mesoporous Mater. 2021, 310, 110597. [Google Scholar] [CrossRef]
- Benmaati, A.; Boukoussa, B.; Hadjadj Aoul, R.; Hachemaoui, M.; Kerbadou, R.M.; Habib Zahmani, H.; Hacini, S. Insights into Catalytic Reduction of Organic Pollutants Catalyzed by Nanoparticles Supported on Zeolite Clinoptilolite. Silicon 2022, 14, 8831–8843. [Google Scholar] [CrossRef]
- Boukoussa, B.; Cherdouane, K.R.; Zegai, R.; Mokhtar, A.; Hachemaoui, M.; Issam, I.; Iqbal, J.; Patole, S.P.; Zeggai, F.Z.; Hamacha, R.; et al. Preparation of Activated Carbon-Metal Nanoparticle Composite Materials for the Catalytic Reduction of Organic Pollutants. Surf. Interfaces 2024, 44, 103622. [Google Scholar] [CrossRef]
- Hakiki, A.; Boukoussa, B.; Kibou, Z.; Terrab, I.; Ghomari, K.; Choukchou-Braham, N.; Hamacha, R.; Bengueddach, A.; Azzouz, A. Correlation of Hydrophilic Character and Surface Basicity of Exchanged Omega-Catalyzed MCR Process. Thermochim. Acta 2018, 662, 108–115. [Google Scholar] [CrossRef]
- An, X.; Li, K.; Tang, J. Cu2O/Reduced Graphene Oxide Composites for the Photocatalytic Conversion of CO2. ChemSusChem 2014, 7, 1086–1093. [Google Scholar] [CrossRef]
- Khan, A.; Rashid, A.; Younas, R.; Chong, R. A Chemical Reduction Approach to the Synthesis of Copper Nanoparticles. Int. Nano Lett. 2016, 6, 21–26. [Google Scholar] [CrossRef]
- Shaikhaldein, H.O.; Al-Qurainy, F.; Nadeem, M.; Khan, S.; Tarroum, M.; Salih, A.M. Biosynthesis and Characterization of Silver Nanoparticles Using Ochradenus Arabicus and Their Physiological Effect on Maerua Oblongifolia Raised in Vitro. Sci. Rep. 2020, 10, 17569. [Google Scholar] [CrossRef]
- CO2 Adsorption Properties of Ion-Exchanged Zeolite Y Prepared from Natural Clays—IOPscience. Available online: https://iopscience.iop.org/article/10.1088/2053-1591/aa6465 (accessed on 26 February 2024).
- Shah, S.A.; Ahmad, Z.; Khan, S.A.; Al-Ghamdi, Y.O.; Bakhsh, E.M.; Khan, N.; ur Rehman, M.; Jabli, M.; Khan, S.B. Biomass Impregnated Zero-Valent Ag and Cu Supported-Catalyst: Evaluation in the Reduction of Nitrophenol and Discoloration of Dyes in Aqueous Medium. J. Organomet. Chem. 2021, 938, 121756. [Google Scholar] [CrossRef]
- Asli, B.; Abdelkrim, S.; Zahraoui, M.; Mokhtar, A.; Hachemaoui, M.; Bennabi, F.; Ahmed, A.B.; Sardi, A.; Boukoussa, B. Catalytic Reduction and Antibacterial Activity of MCM-41 Modified by Silver Nanoparticles. Silicon 2022, 14, 12587–12598. [Google Scholar] [CrossRef]
- Ghosh, B.K.; Hazra, S.; Naik, B.; Ghosh, N.N. Preparation of Cu Nanoparticle Loaded SBA-15 and Their Excellent Catalytic Activity in Reduction of Variety of Dyes. Powder Technol. 2015, 269, 371–378. [Google Scholar] [CrossRef]
- Chishti, A.N.; Ma, Z.; Liu, Y.; Chen, M.; Gautam, J.; Guo, F.; Ni, L.; Diao, G. Synthesis of Highly Efficient and Magnetically Separable Fe3O4@C-TiO2-Ag Catalyst for the Reduction of Organic Dyes and 4-Nitrophenol. Colloids Surf. A Physicochem. Eng. Asp. 2021, 631, 127694. [Google Scholar] [CrossRef]
- Benali, F.; Boukoussa, B.; Issam, I.; Iqbal, J.; Mokhtar, A.; Hachemaoui, M.; Habeche, F.; Hacini, S.; Abboud, M. Zinc Nanoparticles Encapsulated in Porous Biopolymer Beads for Reduction of Water Pollutants and Antimicrobial Activity. Int. J. Biol. Macromol. 2023, 248, 125832. [Google Scholar] [CrossRef]
- Bernaoui, C.R.; Bendraoua, A.; Zaoui, F.; Gallardo, J.J.; Navas, J.; Boudia, R.A.; Djediai, H.; Goual, N.e.H.; Adjdir, M. Synthesis and Characterization of NiFe2O4 Nanoparticles as Reusable Magnetic Nanocatalyst for Organic Dyes Catalytic Reduction: Study of the Counter Anion Effect. Mater. Chem. Phys. 2022, 292, 126793. [Google Scholar] [CrossRef]
- Benali, F.; Boukoussa, B.; Ismail, I.; Hachemaoui, M.; Iqbal, J.; Taha, I.; Cherifi, Z.; Mokhtar, A. One Pot Preparation of CeO2@Alginate Composite Beads for the Catalytic Reduction of MB Dye: Effect of Cerium Percentage. Surf. Interfaces 2021, 26, 101306. [Google Scholar] [CrossRef]
- Habeche, F.; Boukoussa, B.; Issam, I.; Mokhtar, A.; Lu, X.; Iqbal, J.; Benali, F.; Hacini, S.; Hachemaoui, M.; Abboud, M. Synthesis and Application of Metal Nanoparticles-Loaded Mesoporous Silica toward the Reduction of Organic Pollutants in a Simple and Binary System. Inorg. Chem. Commun. 2023, 151, 110572. [Google Scholar] [CrossRef]
- Habeche, F.; Boukoussa, B.; Issam, I.; Mokhtar, A.; Lu, X.; Iqbal, J.; Hacini, S.; Hachemaoui, M.; Bengueddach, A.; Hamacha, R. Catalytic Reduction of Organic Pollutants, Antibacterial and Antifungal Activities of AgNPs@CuO Nanoparticles–Loaded Mesoporous Silica. Environ. Sci. Pollut. Res. 2022, 11, 30855–30873. [Google Scholar] [CrossRef]
- Zhang, N.; Peng, S.; Liu, Z.; Li, Y.; Huang, J.; Li, J.; Wan, H.; Zhou, S.; Gao, Z.; Chen, T. Ag NPs Decorated on the Magnetic Fe3O4@PDA as Efficient Catalyst for Organic Pollutants Removal and as Effective Antimicrobial Agent for Microbial Inhibition. J. Alloys Compd. 2022, 928, 167257. [Google Scholar] [CrossRef]
- Bogireddy, N.K.R.; Hoskote Anand, K.K.; Mandal, B.K. Gold Nanoparticles—Synthesis by Sterculia Acuminata Extract and Its Catalytic Efficiency in Alleviating Different Organic Dyes. J. Mol. Liq. 2015, 211, 868–875. [Google Scholar] [CrossRef]
- Cui, X.; Zheng, Y.; Tian, M.; Dong, Z. Palladium Nanoparticles Supported on SiO2@Fe3O4@m-MnO2 Mesoporous Microspheres as a Highly Efficient and Recyclable Catalyst for Hydrodechlorination of 2,4-Dichlorophenol and Reduction of Nitroaromatic Compounds and Organic Dyes. Mol. Catal. 2017, 433, 202–211. [Google Scholar] [CrossRef]
- Das, R.; Sypu, V.S.; Paumo, H.K.; Bhaumik, M.; Maharaj, V.; Maity, A. Silver Decorated Magnetic Nanocomposite (Fe3O4@PPy-MAA/Ag) as Highly Active Catalyst towards Reduction of 4-Nitrophenol and Toxic Organic Dyes. Appl. Catal. B Environ. 2019, 244, 546–558. [Google Scholar] [CrossRef]
- Das, D.; Sarkar, R.; Mukherjee, S.; Chattopadhyay, K.K. Sodium Borohydride Assisted Reduction of Toxic Pollutants by Silver Coordinated Melamine Based Polymeric Material. Mater. Today Proc. 2021, 44, 444–452. [Google Scholar] [CrossRef]
- Fu, Y.; Xu, P.; Huang, D.; Zeng, G.; Lai, C.; Qin, L.; Li, B.; He, J.; Yi, H.; Cheng, M.; et al. Au Nanoparticles Decorated on Activated Coke via a Facile Preparation for Efficient Catalytic Reduction of Nitrophenols and Azo Dyes. Appl. Surf. Sci. 2019, 473, 578–588. [Google Scholar] [CrossRef]
- Shehabeldine, A.M.; Salem, S.S.; Ali, O.M.; Abd-Elsalam, K.A.; Elkady, F.M.; Hashem, A.H. Multifunctional Silver Nanoparticles Based on Chitosan: Antibacterial, Antibiofilm, Antifungal, Antioxidant, and Wound-Healing Activities. J. Fungi 2022, 8, 612. [Google Scholar] [CrossRef]

| Dyes | Catalyst | Catalyst Mass (mg) | [NaBH4] (mM) | Reaction Time (min) | Kapp (min−1) | Ref. |
|---|---|---|---|---|---|---|
| MB | AgNPS-MCM-41 | 3 | 6.8 | 7 | 0.29 | [50] |
| Cu@SBA-3 | 3 | 6.8 | 3 | 2.944 | [32] | |
| Cu@SBA-3 | 3 | 6.8 | 3 | 2.944 | [32] | |
| 12.5Cu@SBA-15 | 1 | 20 | 8 | 0.51 | [51] | |
| Fe3O4@C-TiO2-Ag | 10 | / | 10 | 0.38 | [52] | |
| Cu(4%)-ALG(ZnNPs) | 5.1 | 1.6 | 09 | 0.798 | [53] | |
| Ag/Y | 3 | 5 | 4 | 1.882 | This study | |
| OG | NFCP | 2 | 20 | 4 | 0.4514 | [54] |
| NFSP | 2 | 20 | 4 | 0.4227 | [54] | |
| Cu(4%)-ALG(ZnNPs) | 5.1 | 1.6 | 19 | 0.252 | [53] | |
| Ag/Y | 3 | 5 | 6 | 1.115 | This study |
| Bacteria | Zn/Y | Cu/Y | Ag/Y |
|---|---|---|---|
| Escherichia coli ATCC 25922 | 23 | 15 | 16 |
| Staphylococcus aureus ATCC 25923 | 21 | 20 | 19 |
| Staphylococcus aureus ATCC 43300 | 19 | 25 | 16 |
| Pseudomonas aeruginosa A22 | 15 | 14 | 25 |
Disclaimer/Publisher’s Note: The statements, opinions and data contained in all publications are solely those of the individual author(s) and contributor(s) and not of MDPI and/or the editor(s). MDPI and/or the editor(s) disclaim responsibility for any injury to people or property resulting from any ideas, methods, instructions or products referred to in the content. |
© 2025 by the authors. Licensee MDPI, Basel, Switzerland. This article is an open access article distributed under the terms and conditions of the Creative Commons Attribution (CC BY) license (https://creativecommons.org/licenses/by/4.0/).
Share and Cite
Benaouda, H.; Bouchiba, N.; Hachemaoui, M.; Abad-López, J.; Bennabi, F.; Mokhtar, A.; Hasnaoui, M.A.; Ismail, I.; Abboud, M.; Boukoussa, B. MNP (M = Zn, Cu, and Ag) Catalyst Embedded onto Zeolite Y Surface for Efficient Dye Reduction and Antimicrobial Activity. Catalysts 2025, 15, 407. https://doi.org/10.3390/catal15050407
Benaouda H, Bouchiba N, Hachemaoui M, Abad-López J, Bennabi F, Mokhtar A, Hasnaoui MA, Ismail I, Abboud M, Boukoussa B. MNP (M = Zn, Cu, and Ag) Catalyst Embedded onto Zeolite Y Surface for Efficient Dye Reduction and Antimicrobial Activity. Catalysts. 2025; 15(5):407. https://doi.org/10.3390/catal15050407
Chicago/Turabian StyleBenaouda, Hamza, Nabila Bouchiba, Mohammed Hachemaoui, José Abad-López, Farid Bennabi, Adel Mokhtar, Mohamed Abdelkrim Hasnaoui, Issam Ismail, Mohamed Abboud, and Bouhadjar Boukoussa. 2025. "MNP (M = Zn, Cu, and Ag) Catalyst Embedded onto Zeolite Y Surface for Efficient Dye Reduction and Antimicrobial Activity" Catalysts 15, no. 5: 407. https://doi.org/10.3390/catal15050407
APA StyleBenaouda, H., Bouchiba, N., Hachemaoui, M., Abad-López, J., Bennabi, F., Mokhtar, A., Hasnaoui, M. A., Ismail, I., Abboud, M., & Boukoussa, B. (2025). MNP (M = Zn, Cu, and Ag) Catalyst Embedded onto Zeolite Y Surface for Efficient Dye Reduction and Antimicrobial Activity. Catalysts, 15(5), 407. https://doi.org/10.3390/catal15050407










